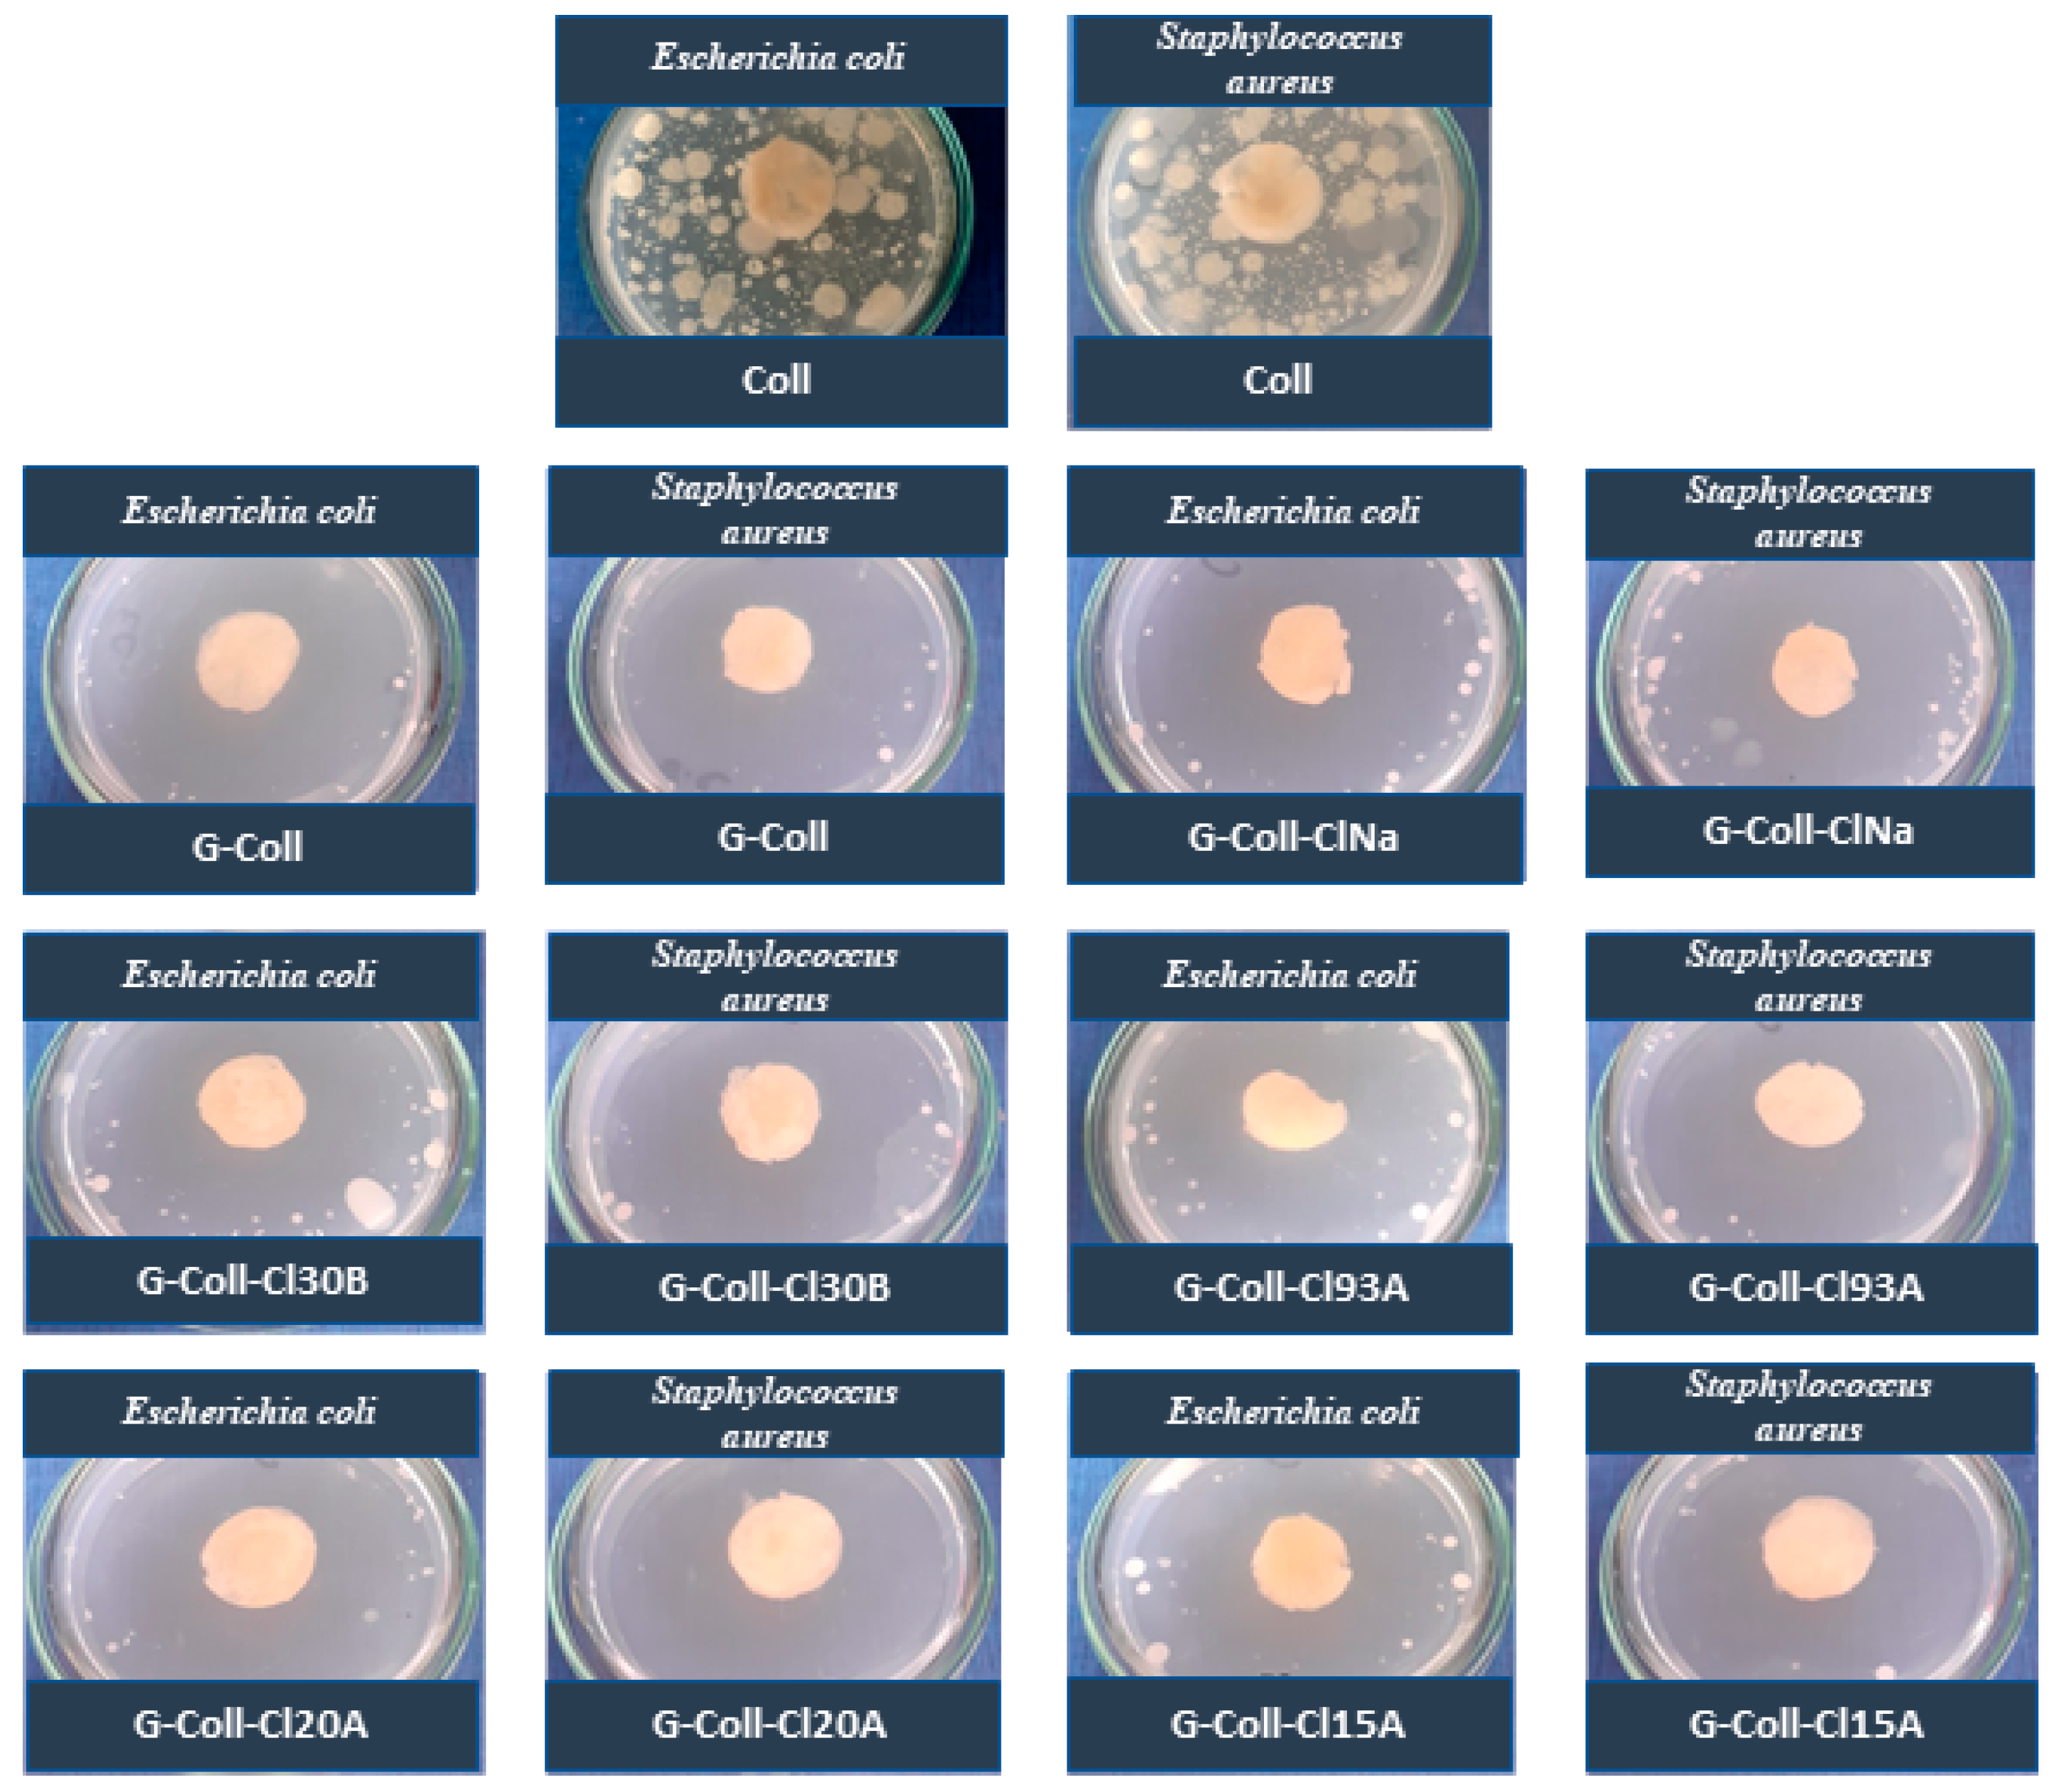

Development of New Collagen/Clay Composite Biomaterials
Abstract
:1. Introduction
2. Results and Discussion
2.1. FTIR Analyses
2.2. X-ray Diffraction Analyses
2.3. SEM Analyses
2.4. Thermogravimetrical Analyses
2.5. Swelling Studies
2.6. Biodegradation
2.7. Mechanical Tests
2.8. Drug Release
2.9. Antimicrobial Activity
2.10. Cellular Viability—MTT Tests
3. Materials and Methods
3.1. Materials
3.2. Preparation of New Collagen/Clay Composite Biomaterials
3.3. Methods
3.3.1. Fourier-Transform Infrared Spectroscopy (FTIR)
3.3.2. X-ray Diffraction (XRD)
3.3.3. Scanning Electron Microscopy (SEM)
3.3.4. Thermo Gravimetric Analysis (TGA)
3.3.5. Swelling Ratio
3.3.6. Biodegradation
3.3.7. Mechanical Tests
3.3.8. Drug Release
3.3.9. Antimicrobial Activity
3.3.10. Cellular Viability—MTT Tests
4. Conclusions
Author Contributions
Funding
Institutional Review Board Statement
Informed Consent Statement
Data Availability Statement
Acknowledgments
Conflicts of Interest
References
- Reyna-Valencia, A.; Chevallier, P.; Mantovani, D. Development of a collagen/clay nanocomposite biomaterial. Mater. Sci. Forum 2012, 706, 461–466. [Google Scholar] [CrossRef]
- Cui, Z.K.; Kim, S.; Baljon, J.J.; Wu, B.M.; Aghaloo, T.; Lee, M. Microporous methacrylated glycol chitosan montmorillonite nanocomposite hydrogel for bone tissue engineering. Nat. Commun. 2019, 10, 3523. [Google Scholar] [CrossRef] [PubMed] [Green Version]
- Shen, Y.; Zhan, Y.; Tang, J.; Xu, P.; Johnson, P.A.; Radosz, M.; Van Kirk, E.A.; Murdoch, W.J. Multifunctioning pH-responsive nanoparticle from hierarchical self-assembly of polymer brush for cancer drug delivery. AIChE J. 2008, 54, 2979–2989. [Google Scholar] [CrossRef]
- Geanaliu-Nicolae, R.E.; Andronescu, E. Blended natural support materials-collagen based hydrogels used in biomedicine. Materials 2020, 13, 5641. [Google Scholar] [CrossRef] [PubMed]
- An, B.; Lin, Y.-S.; Brodsky, B. Collagen interactions: Drug design and delivery. Adv. Drug Deliv. Rev. 2016, 97, 69–84. [Google Scholar] [CrossRef] [PubMed]
- Chvapil, M.; Kronenthal, R.L.; Van Winkle, W. Medical and surgical applications of collagen. Int. Rev. Connect. Tissue Res. 1973, 6, 1–61. [Google Scholar]
- Antoine, E.E.; Vlachos, P.P.; Rylander, M.N. Review of collagen I hydrogels for bioengineered tissue microenvironments: Characterization of mechanics, structure, and transport. Tissue Eng. Part B Rev. 2014, 20, 683–696. [Google Scholar] [CrossRef] [Green Version]
- Ahmadi, F.; Oveisi, Z.; Mohammadi-Samani, S.; Amoozgar, Z. Chitosan based hydrogels: Characteristics and pharmaceutical applications. Res. Pharm. Sci. 2015, 10, 1–16. [Google Scholar]
- Chvapil, M. Collagen sponge: Theory and practice of medical applications. J. Biomed. Mater. Res. 1977, 11, 721–741. [Google Scholar] [CrossRef]
- Bahram, M.; Mohseni, N.; Moghtader, M. An Introduction to Hydrogels and Some Recent Applications; IntechOpen: London, UK, 2016. [Google Scholar]
- Parenteau-Bareil, R.; Gauvin, R.; Berthod, F. Collagen-based biomaterials for tissue engineering applications. Materials 2010, 3, 1863–1887. [Google Scholar] [CrossRef] [Green Version]
- Andonegi, M.; Heras, K.L.; Santos-Vizcaino, E.; Igartua, M.; Hernandez, R.M.; de la Caba, K.; Guerrero, P. Structure-properties relationship of chitosan/collagen films with potential for biomedical applications. Carbohydr. Polym. 2020, 237, 116159. [Google Scholar] [CrossRef] [PubMed]
- Lin, K.; Zhang, D.; Macedo, M.H.; Cui, W.; Sarmento, B.; Shen, G. Advanced collagen-based biomaterials for regenerative biomedicine. Adv. Funct. Mater. 2019, 29, 1804943. [Google Scholar] [CrossRef]
- Valencia, G.A.; Luciano, C.G.; Lourenço, R.V.; Quinta Barbosa Bittante, A.M.; do Amaral Sobral, P.J. Morphological and physical properties of nano-biocomposite films based on collagen loaded with laponite. Food Packag. Shelf Life 2019, 19, 24–30. [Google Scholar] [CrossRef]
- Albu, M.G.; Titorencu, I.; Ghica, M.V. Collagen-based drug delivery systems for tissue engineering. Biomater. Appl. Nanomed. 2011, 17, 333–358. [Google Scholar]
- Cao, H.; Xu, S.Y. Purification and characterization of type II collagen from chick sternal cartilage. Food Chem. 2008, 108, 439–445. [Google Scholar] [CrossRef] [PubMed]
- Gelse, K.; Poschl, E.; Aigner, T. Collagens-structure, function, and biosynthesis. Adv. Drug Deliv. Rev. 2003, 55, 1531–1546. [Google Scholar] [CrossRef] [PubMed] [Green Version]
- Silva, T.H.; Moreirasilva, J.; Marques, A.L.; Domingues, A.; Bayon, Y.; Reis, R.L. Marine origin collagens and its potential applications. Mar. Drugs 2014, 12, 5881–5901. [Google Scholar] [CrossRef] [PubMed] [Green Version]
- Fulya, B.; Onur, A.; Merih, O.; Funda, T.; Ozge, B.; Ozkan, A. Effects of native type II collagen treatment on knee osteoarthritis: A randomized controlled trial. Eurasian J. Med. 2016, 48, 95–101. [Google Scholar]
- Marin, M.M.; Albu Kaya, M.G.; Vlasceanu, G.M.; Ghitman, J.; Radu, I.C.; Iovu, H. The effect of crosslinking agents on the properties of type II collagen biomaterials. Mater. Plast. 2020, 57, 166–180. [Google Scholar] [CrossRef]
- Su, D.; Wang, C.; Cai, S.; Mu, C.; Li, D.; Lin, W. Influence of palygorskite on the structure and thermal stability of collagen. Appl. Clay Sci. 2012, 62, 41–46. [Google Scholar] [CrossRef]
- Carretero, M.I.; Gomes, C.S.F.; Tateo, F. Clays, drugs, and human health. In Developments in Clay Science; Bergaya, F., Lagaly, G., Eds.; Elsevier: Cambridge, MA, USA, 2013; Volume 5. [Google Scholar]
- Zhou, Y.; LaChance, A.M.; Smith, A.T.; Cheng, H.F.; Liu, Q.F.; Sun, L.Y. Multifunctional materials: Strategic design of clay-based multifunctional materials: From natural minerals to nanostructured membranes. Adv. Funct. Mater. 2019, 29, 1807611. [Google Scholar] [CrossRef]
- Mousa, M.; Evans, N.; Oreffo, R.O.; Dawson, J. Clay nanoparticles for regenerative medicine and biomaterial design: A review of clay bioactivity. Biomaterials 2018, 159, 204–2014. [Google Scholar] [CrossRef] [Green Version]
- Gaharwar, A.K.; Cross, L.M.; Peak, C.W.; Gold, K.; Carrow, J.K.; Brokesh, A.; Singh, K.A. 2D nanoclay for biomedical applications: Regenerative medicine, therapeutic delivery, and additive manufacturing. Adv. Mater. 2019, 31, 1900332. [Google Scholar] [CrossRef]
- Liu, M.X.; Fakhrullin, R.; Novikov, A.; Panchal, A.; Lvov, Y. Tubule nanoclay-organic heterostructures for biomedical applications. Macromol. Biosci. 2019, 19, 1800419. [Google Scholar] [CrossRef] [PubMed]
- Chimene, D.; Kaunas, R.; Gaharwar, A.K. Hydrogel bioink reinforcement for additive manufacturing: A focused review of emerging strategies. Adv. Mater. 2019, 32, 1902026. [Google Scholar] [CrossRef]
- Yu, X.; Guo, L.; Liu, M.; Cao, X.; Shang, S.; Liu, Z.; Huang, D.; Cao, Y.; Cui, F.; Tian, L. Callicarpa nudiflora loaded on chitosan-collagen/organomontmorillonite composite membrane for antibacterial activity of wound dressing. Int. J. Biol. Macromol. 2018, 120, 2279–2284. [Google Scholar] [CrossRef]
- Wang, S.G.; Zheng, F.Y.; Huang, Y.P.; Fang, Y.T.; Shen, M.W.; Zhu, M.F.; Shi, X.Y. Encapsulation of amoxicillin within laponite-doped poly(lactic-co-glycolic acid) nanofibers: Preparation, characterization, and antibacterial activity. ACS Appl. Mater. Interfaces 2012, 4, 6393. [Google Scholar] [CrossRef]
- Pierchala, M.K.; Makaremi, M.; Tan, H.L.; Pushpamalar, J.; Muniyandy, S.; Solouk, A.; Lee, S.M.; Pasbakhsh, P. Nanotubes in nanofibers: Antibacterial multilayered polylactic acid/halloysite/gentamicin membranes for bone regeneration application. Appl. Clay Sci. 2018, 160, 95–105. [Google Scholar] [CrossRef]
- Torres, E.; Dominguez-Candela, I.; Castello-Palacios, S.; Valles-Lluch, A.; Fombuena, V. Development and characterization of polyester and acrylate-based composites with hydroxyapatite and halloysite nanotubes for medical applications. Polymers 2020, 12, 1703. [Google Scholar] [CrossRef] [PubMed]
- Nistor, M.T.; Vasile, C.; Chiriac, A.P. Hybrid collagen-based hydrogels with embedded montmorillonite nanoparticles. Mater. Sci. Eng. C 2015, 53, 212–221. [Google Scholar] [CrossRef] [PubMed]
- Jayrajsinh, S.; Shankar, G.; Agrawal, Y.K.; Bakre, L. Montmorillonite nanoclay as a multifaceted drug delivery carrier: A review. J. Drug Deliv. Sci. Technol. 2017, 39, 200–209. [Google Scholar] [CrossRef]
- Meirelles, L.M.A.; Raffin, F.N. Clay and polymer-based composites applied to drug release: A scientific and technological prospection. J. Pharm. Pharm. Sci. 2017, 20, 115–134. [Google Scholar] [CrossRef] [Green Version]
- Sharma, A.K.; Mortensen, A.; Schmidt, B.; Frandsen, H.; Hadrup, N.; Larsen, E.H.; Binderup, M.L. In-vivo study of genotoxic and inflammatory effects of the organo-modified Montmorillonite Cloisite® 30B. Mutat. Res. Genet. Toxicol. Environ. Mutagenesis 2014, 770, 66–71. [Google Scholar] [CrossRef]
- Dawson, J.I.; Oreffo, R.O.C. Clay: New opportunities for tissue regeneration and biomaterial design. Adv. Mater. 2013, 25, 4069–4086. [Google Scholar] [CrossRef]
- Takeno, H.; Nagai, S. Mechanical properties and structures of clay-polyelectrolyte blend hydrogels. Gels 2018, 4, 71. [Google Scholar] [CrossRef] [Green Version]
- Liu, X.; Lu, X.; Su, Y.; Kun, E.; Zhang, F. Clay-polymer nanocomposites prepared by reactive melt extrusion for sustained drug release. Pharmaceutics 2020, 12, 51. [Google Scholar] [CrossRef] [Green Version]
- Firdaus, M.Y.; Octaviani, H.; Herlini, H.; Fatimah, N.; Mulyaningsih, T.; Fairuuz, Z.; Bayu, A. Review: The comparison of clay modifier (cloisite types) in various epoxy-clay nanocomposite synthesis methods. Mediterr. J. Chem. 2021, 11, 54–74. [Google Scholar] [CrossRef]
- Bak, S.Y.; Lee, S.W.; Choi, C.H.; Kim, H.W. Assessment of the influence of acetic acid residue on type I collagen during isolation and characterization. Materials 2018, 11, 2518. [Google Scholar] [CrossRef] [PubMed] [Green Version]
- Leu Alexa, R.; Iovu, H.; Trica, B.; Zaharia, C.; Serafim, A.; Alexandrescu, E.; Radu, I.C.; Vlasceanu, G.; Preda, S.; Ninciuleanu, C.M.; et al. Assessment of naturally sourced mineral clays for the 3D printing of biopolymer-based nanocomposite inks. Nanomaterials 2021, 11, 703. [Google Scholar] [CrossRef] [PubMed]
- García-Villén, F.; Ruiz-Alonso, S.; Lafuente-Merchan, M.; Gallego, I.; Sainz-Ramos, M.; Saenz-del-Burgo, L.; Pedraz, J.L. Clay minerals as bioink ingredients for 3D printing and 3D bioprinting: Application in tissue engineering and regenerative medicine. Pharmaceutics 2021, 13, 1806. [Google Scholar] [CrossRef]
- Leu Alexa, R.; Ianchis, R.; Savu, D.; Temelie, M.; Trica, B.; Serafim, A.; Vlasceanu, G.M.; Alexandrescu, E.; Preda, S.; Iovu, I. 3D printing of alginate-natural clay hydrogel-based nanocomposites. Gels 2021, 7, 211. [Google Scholar] [CrossRef]
- Ianchis, R.; Ninciuleanu, C.M.; Gifu, I.C.; Alexandrescu, E.; Nistor, C.L.; Nitu, S.; Petcu, C. Hydrogel-clay nanocomposites as carriers for controlled release. Curr. Med. Chem. 2020, 27, 919–954. [Google Scholar] [CrossRef]
- Shen, J.; Li, N.; Ye, M. Preparation and characterization of dual-sensitive double network hydrogels with clay as a physical crosslinker. Appl. Clay Sci. 2015, 103, 40–45. [Google Scholar] [CrossRef]
- Pereira, K.A.B.; Aguiar, K.L.N.P.; Oliveira, P.F.; Vicente, B.M.; Pedroni, L.G.; Mansur, C.R.E. Synthesis of hydrogel nanocomposites based on partially hydrolysed polyacrylamide, polyethyleneimine, and modified clay. ACS Omega 2020, 5, 4759–4769. [Google Scholar] [CrossRef] [PubMed]
- León-Mancilla, B.H.; Araiza-Téllez, M.A.; Flores-Flores, J.O.; Piña-Barba, M.C. Physico-chemical characterization of collagen scaffolds for tissue engineering. J. Appl. Res. Technol. 2016, 14, 77–85. [Google Scholar] [CrossRef]
- Coppola, B.; Cappetti, N.; Di Maio, L.; Scarfato, P.; Incarnato, L. 3D printing of PLA/clay nanocomposites: Influence of printing temperature on printed samples properties. Materials 2018, 11, 1947. [Google Scholar] [CrossRef] [Green Version]
- Cao, X.; Wang, J.; Liu, M.; Chen, Y.; Cao, Y.; Yu, X. Chitosan-collagen/organomontmorillonite scaffold for bone tissue engineering. Front. Mater. Sci. 2015, 9, 405–412. [Google Scholar] [CrossRef]
- Mertz, E.L.; Leikin, S. Interactions of inorganic phosphate and sulfate anions with collagen. Biochemistry 2004, 43, 14901–14912. [Google Scholar] [CrossRef] [PubMed]
- Del Prado Audelo, M.L.; Gómez Lizárraga, K.K.; Gómez, D.M.G.; Martínez Hernández, H.; Rodríguez Fuentes, N.; Castell Rodríguez, A.E.; Montufar, E.B.; Piña Barba, M.C. Development of collagen-EDC scaffolds for skin tissue engineering: Physicochemical and biological characterization. Int. J. Eng. Res. Sci. 2016, 2, 73–83. [Google Scholar]
- Le, H.; Xu, W.; Zhuang, X.; Chang, F.; Wang, Y.; Ding, J. Mesenchymal stem cells for cartilage regeneration. J. Tissue Eng. 2020, 1, 1–22. [Google Scholar] [CrossRef]
- Ianchis, R.; Rosca, I.D.; Ghiurea, M.; Spataru, C.I.; Nicolae, C.A.; Gabor, R.; Raditoiu, V.; Preda, S.; Fierascu, R.C.; Donescu, D. Synthesis and properties of new epoxy-organolayered silicates nanocomposites. Appl. Clay Sci. 2015, 103, 28–33. [Google Scholar] [CrossRef]
- Munteanu, T.; Ninciuleanu, C.M.; Gifu, I.C.; Trica, B.; Alexandrescu, E.; Gabor, A.R.; Preda, S.; Petcu, C.; Nistor, C.L.; Nitu, S.G.; et al. The effect of clay type on the physicochemical properties of new hydrogelclay nanocomposites. In Current Topics in the Utilization of Clay in Industrial and Medical Applications; Zoveidavianpoor, M., Ed.; IntechOpen: London, UK, 2018; pp. 147–165. [Google Scholar]
- Zhang, L.; Hu, J.; Athanasiou, K.A. The role of tissue engineering in articular cartilage repair and regeneration. Crit. Rev. Biomed. Eng. 2009, 37, 1–57. [Google Scholar] [CrossRef]
- Lukáč, P.; Hartinger, J.M.; Mlček, M.; Popková, M.; Suchý, T.; Šupová, M.; Závora, J.; Adámková, V.; Benáková, H.; Slanař, O.; et al. A novel gentamicin-releasing wound dressing prepared from freshwater fish Cyprinus carpio collagen cross-linked with carbodiimide. J. Bioact. Compat. Polym. 2019, 34, 246–262. [Google Scholar] [CrossRef]
- Nemu, R.P.; Adhyapak, A.; Mannur, V.S.; Mastiholimath, V.S.; Powalkar, T. Development and validation of spectrophotometric method for determination of gentamicin and curcumin in bulk powder. Int. J. Pharm. Sci. Rev. Res. 2019, 59, 109–113. [Google Scholar]
- Wali, A.; Gorain, M.; Inamdar, S.; Kundu, G.; Badiger, M. In vivo wound healing performance of halloysite clay and gentamicin-incorporated cellulose ether-PVA electrospun nanofiber mats. ACS Appl. Biol. Mater. 2019, 2, 4324–4334. [Google Scholar] [CrossRef]
- Marin, M.M.; Albu-Kaya, M.G.; Stavarache, C.E.; Constantinescu, R.R.; Chelaru, C.; Ghitman, J.; Iovu, H. Extraction and studies on the properties of type II collagen as potential biomaterial in cartilage repair. UPB Sci. Bull. Ser. B 2021, 83, 229–238. [Google Scholar]
- Ciapetti, G.; Cenni, E.; Pratelli, L.; Pizzoferrato, A. In vitro evaluation of cell/biomaterial interaction by MTT assay. Biomaterials 1993, 14, 359–364. [Google Scholar] [CrossRef]
- Marin, M.M.; Albu Kaya, M.; Marin, S.; Danila, E.; Bumbeneci, G.; Aldea, C.; Coara, G.; Albu, L. Process for Obtaining Collagen Extracts from Bovine Cartilage for Medical Applications; CBI OSIM A 00840/26.10.2018; OSIM: Bucharest, Romania, 2018. [Google Scholar]
- Radu, I.C.; Zaharia, C.; Hudita, A.; Tanasa, E.; Ginghina, O.; Marin, M.; Galateanu, B.; Costache, M. In vitro interaction of doxorubicin-loaded silk sericin nanocarriers with mcf-7 breast cancer cells leads to DNA damage. Polymers 2021, 13, 2047. [Google Scholar] [CrossRef] [PubMed]
- Marin, M.M.; Albu Kaya, M.; Iovu, H.; Stavarache, C.E.; Chelaru, C.; Constantinescu, R.R.; Dinu-Pîrvu, C.E.; Ghica, M.V. Obtaining, evaluation, and optimization of doxycycline-loaded microparticles intended for the local treatment of infectious arthritis. Coatings 2020, 10, 990. [Google Scholar] [CrossRef]

| Sample | T10% (°C) | T50% (°C) | Water Loss Step | Thermal Degradation Step | Residual Mass (%) |
|---|---|---|---|---|---|
| Tmax% (°C) | Tmax% (°C) | ||||
| Coll | 257.6 | 348.5 | 56.3 | 319.3 | 23.82 |
| Coll-ClNa | 263.7 | 393.2 | 64.8 | 327.2 | 37.59 |
| Coll-Cl30B | 271.6 | 372.7 | 61.0 | 326.1 | 33.51 |
| Coll-Cl93A | 271.2 | 364.2 | 64.3 | 329.0 | 30.44 |
| Coll-Cl20A | 259.0 | 359.7 | 56.3 | 326.6 | 29.41 |
| Coll-Cl15A | 262.7 | 357.6 | 58.7 | 326.5 | 29.76 |
| Sample | Sample Distortion under Stress Condition (Force Applied = 5 N), (%) | Revert after 10 s, (%) | Revert after 30 min, (%) |
|---|---|---|---|
| Coll | 62.79 | 56.45 | 88.02 |
| Coll-ClNa | 20.99 | 90.66 | 99.12 |
| Coll-Cl30B | 25.68 | 89.95 | 94.34 |
| Coll-Cl93A | 49.80 | 68.15 | 90.52 |
| Coll-Cl20A | 58.63 | 85.12 | 93.80 |
| Coll-Cl15A | 56.08 | 56.45 | 88.02 |
| Sample | Inhibition Area (mm) | Bacterial Strain | Evaluation | SD (Standard Deviation) for Three Determinations |
|---|---|---|---|---|
| Coll | Absent | Staphylococcus aureus | Insufficient effect | 0 |
| Absent | Escherichia coli | Insufficient effect | 0 | |
| G-Coll | 10 | Staphylococcus aureus | Satisfactory effect | 0.3 |
| 11 | Escherichia coli | Satisfactory effect | 0.1 | |
| G-Coll-ClNa | 7.5 | Staphylococcus aureus | Satisfactory effect | 0.1 |
| 8.5 | Escherichia coli | Satisfactory effect | 0.1 | |
| G-Coll-Cl30B | 6 | Staphylococcus aureus | Satisfactory effect | 0.1 |
| 5 | Escherichia coli | Satisfactory effect | 0.1 | |
| G-Coll-Cl93A | 9.5 | Staphylococcus aureus | Satisfactory effect | 0.1 |
| 3.5 | Escherichia coli | Satisfactory effect | 0.1 | |
| G-Coll-Cl20A | 10.5 | Staphylococcus aureus | Satisfactory effect | 0.1 |
| 9 | Escherichia coli | Satisfactory effect | 0.2 | |
| G-Coll-Cl15A | 10 | Staphylococcus aureus | Satisfactory effect | 0.1 |
| 6 | Escherichia coli | Satisfactory effect | 0.1 |
| Sample | Collagen (%) | ClNa (%) | Cl30B (%) | Cl93A (%) | Cl20A (%) | Cl15A (%) | Gentamicin (GE) (%) | GA (%) |
|---|---|---|---|---|---|---|---|---|
| Coll | 1.5 | - | - | - | - | - | - | 0.16 |
| Coll-ClNa | 1.5 | 0.375 | - | - | - | - | - | 0.16 |
| Coll-Cl30B | 1.5 | - | 0.375 | - | - | - | - | 0.16 |
| Coll-Cl93A | 1.5 | - | - | 0.375 | - | 0.16 | ||
| Coll-Cl20A | 1.5 | - | - | - | 0.375 | - | 0.16 | |
| Coll-Cl15A | 1.5 | - | - | - | - | 0.375 | - | 0.16 |
| G-Coll | 1.5 | - | - | - | - | - | 0.2 | 0.16 |
| G-Coll-ClNa | 1.5 | 0.375 | - | - | - | - | 0.2 | 0.16 |
| G-Coll-Cl30B | 1.5 | - | 0.375 | - | - | - | 0.2 | 0.16 |
| G-Coll-Cl93A | 1.5 | - | - | 0.375 | - | - | 0.2 | 0.16 |
| G-Coll-Cl20A | 1.5 | - | - | - | 0.375 | - | 0.2 | 0.16 |
| G-Coll-Cl15A | 1.5 | - | - | - | - | 0.375 | 0.2 | 0.16 |
Publisher’s Note: MDPI stays neutral with regard to jurisdictional claims in published maps and institutional affiliations. |
© 2021 by the authors. Licensee MDPI, Basel, Switzerland. This article is an open access article distributed under the terms and conditions of the Creative Commons Attribution (CC BY) license (https://creativecommons.org/licenses/by/4.0/).
Share and Cite
Marin, M.M.; Ianchis, R.; Leu Alexa, R.; Gifu, I.C.; Kaya, M.G.A.; Savu, D.I.; Popescu, R.C.; Alexandrescu, E.; Ninciuleanu, C.M.; Preda, S.; et al. Development of New Collagen/Clay Composite Biomaterials. Int. J. Mol. Sci. 2022, 23, 401. https://doi.org/10.3390/ijms23010401
Marin MM, Ianchis R, Leu Alexa R, Gifu IC, Kaya MGA, Savu DI, Popescu RC, Alexandrescu E, Ninciuleanu CM, Preda S, et al. Development of New Collagen/Clay Composite Biomaterials. International Journal of Molecular Sciences. 2022; 23(1):401. https://doi.org/10.3390/ijms23010401
Chicago/Turabian StyleMarin, Maria Minodora, Raluca Ianchis, Rebeca Leu Alexa, Ioana Catalina Gifu, Madalina Georgiana Albu Kaya, Diana Iulia Savu, Roxana Cristina Popescu, Elvira Alexandrescu, Claudia Mihaela Ninciuleanu, Silviu Preda, and et al. 2022. "Development of New Collagen/Clay Composite Biomaterials" International Journal of Molecular Sciences 23, no. 1: 401. https://doi.org/10.3390/ijms23010401
APA StyleMarin, M. M., Ianchis, R., Leu Alexa, R., Gifu, I. C., Kaya, M. G. A., Savu, D. I., Popescu, R. C., Alexandrescu, E., Ninciuleanu, C. M., Preda, S., Ignat, M., Constantinescu, R., & Iovu, H. (2022). Development of New Collagen/Clay Composite Biomaterials. International Journal of Molecular Sciences, 23(1), 401. https://doi.org/10.3390/ijms23010401









